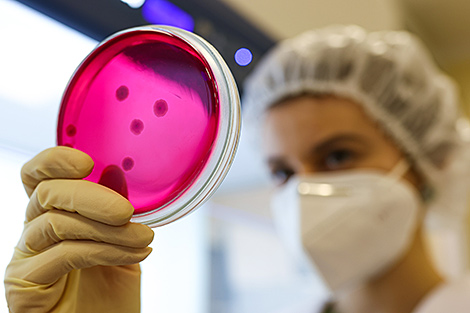
Центр биотехнологий открылся в НАН Беларуси

Бизнес-новости
Центр биотехнологий открылся в НАН Беларуси
В научно-производственном центре биотехнологий
3 декабря, Минск /Корр. БЕЛТА/. Научно-производственный центр биотехнологий открыли в Институте микробиологии Национальной академии наук Беларуси, передает корреспондент БЕЛТА.
"За Академией наук закреплена функция научного сопровождения развития биотехнологической отрасли в стране. По итогам этого года в Беларуси будет произведено биотехнологической продукции примерно на $1 млрд. Мы внедряем все, что разрабатываем. В открывшемся сегодня НПЦ будут использоваться новейшие результаты научных исследований, а дальше эта продукция пойдет в народное хозяйство, в первую очередь сельское", - сказал председатель Президиума НАН Владимир Гусаков.
Центр представляет собой биотехнологическое производство полного цикла, оснащенное современным оборудованием для ферментации микроорганизмов-продуцентов и получения различных товарных форм биопрепаратов. Его проектная мощность - 20,5 т сухих пробиотических препаратов в год (первый пусковой комплекс, который открылся 1 марта 2019 года) и 43,5 т жидких комплексных микробных препаратов для растениеводства в год (второй пусковой комплекс). Использование этого объема пробиотиков в кормопроизводстве обеспечит получение свыше 40 тыс. т высококачественных сбалансированных отечественных кормов для крупного рогатого скота, свиней, птицы, ценных видов рыб, экономический эффект от применения которых составит около Br10 млн в год.





По мнению специалистов, НПЦ будет способствовать насыщению внутреннего рынка конкурентоспособной экологически безопасной биотехнологической продукцией, расширению ее ассортимента, повышению экспортного потенциала и востребованности на мировом рынке, развитию биотехнологий в стране в целом. "Цель Академии наук - не только проводить фундаментальные и прикладные исследования, но и иметь в каждом институте инновационное производство, продавать продукцию", - подчеркнул Владимир Гусаков.
Работа Института микробиологии НАН ориентирована на создание конкурентоспособных биотехнологий получения медицинских и ветеринарных препаратов, пищевых и кормовых добавок, средств защиты растений и биоудобрений, а также на защиту окружающей среды от промышленных загрязнений, что соответствует приоритетным направлениям научной, научно-технической и инновационной деятельности в Беларуси. "Хотелось бы, чтобы наши разработки не лежали на полке, а где-то применялись. Мы целенаправленно идем по этому пути. И открытие центра - важный шаг в этом направлении. Он позволяет реализовать наши идеи вплоть до выпуска продукции на рынок", - отметила директор Института микробиологии НАН Эмилия Коломиец.







 версия для печати
версия для печати сделать стартовой
сделать стартовой добавить в избранное
добавить в избранное

